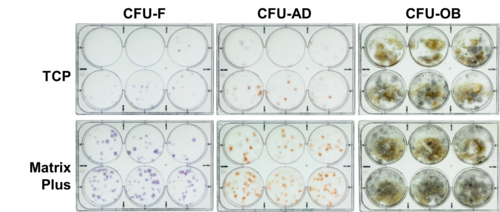

Zellbiologie
Matrizes für Zellreifung und Zellkultur
In Zusammenarbeit mit unseren Partnerfirmen StemBioSys und Jellagen können wir Ihnen die neuesten Matrixsysteme für die 3D-Zellkultur und Expansion Ihrer Zellen anbieten.
CELLvo™ Matrix Plus von StemBioSys
CELLvo™ Matrix Plus ist die nächste Generation der CELLvo™ Matrix-Technologie. CELLvo™-Matrizen sind die einzigen Substrate, die darauf abzielen, sowohl biochemische als auch strukturelle und mechanische Bedingungen der nativen Nische zu kopieren, indem sie die extrazelluläre Matrix intakt lassen. Zellabgeleitete Matrizen schaffen eine biologisch relevante Kulturumgebung für eine Vielzahl von Zelltypen, indem sie alle Bedingungen, die Zellen in vivo erwarten, in unseren Kulturschalen bereitstellen. Das bedeutet, dass die Zellen nicht auf fremde Kulturbedingungen reagieren, sondern auf die experimentellen Variablen unserer Kunden. Ursprünglich für die Kultur pluripotenter Stammzellen entwickelt, haben wir später entdeckt, dass CELLvo™ Matrix Plus das ideale Substrat für die Reifung und Kultur von Kardiomyozyten ist.
Kürzlich in Nature Scientific Reports veröffentlicht, wurde gezeigt, dass hiPSC-CMs, die auf CELLvo™ Matrix Plus expandiert wurden, die effiziente Entwicklung hochfunktioneller, biologisch relevanter menschlicher Kardiomyozyten fördern, die für die Vorhersage der kardialen Sicherheit von Medikamenten in der frühen Entwicklung nützlich sind. (Block et al., 2020)
VIDEO: Drs. Herron und Block diskutieren die Expansion von hiPSC-CM Zellen auf CELLvo™Matrix Plus

CELLvo™ Matrix Plus unterstützt die iPSC-Expansion
Die Expansion pluripotenter Zellen kann mühsam sein. Vorbeschichtete Platten haben oft eine kurze Haltbarkeit, und das Beschichten von Wells mit anderen Produkten kann eine Herausforderung sein, besonders wenn man mit Small-Well-Formaten arbeitet. CELLvo™ Matrix Plus wird gebrauchsfertig mit den Matrixproteinen geliefert, die sich bereits auf der Oberfläche der Platte befinden. Ein kurzer Rehydrierungsschritt mit PBS ist die einzige Voraussetzung für die Aussaat Ihrer Zellen. Dies eliminiert mögliche Schwankungen beim Beschichten von Hand und spart Ihnen Zeit. In unseren Experimenten unterstützt CELLvo™ Matrix Plus eine vergleichbare Selbsterneuerung von iPSCs im Vergleich zu Matrigel, aber mit größerer Benutzerfreundlichkeit.
Cellvo™ Matrix Plus verbessert das Selbsterneuerungs- und Differenzierungspotenzial von MSCs
Mesenchymale Stammzellen (MSC), die auf CELLvo™ Matrix Plus kultiviert wurden, haben ein verbessertes Selbsterneuerungs- und Differenzierungspotenzial im Vergleich zu TCP. Die Abbildung auf der rechten Seite zeigt dies anhand von CFU-F (Koloniebildung), CFU-AD (adipogene Differenzierung) und CFU-OB (osteogene Differenzierung). Außerdem ist die MSC-Proliferation auf CELLvo™ Matrix Plus im Vergleich zu anderen Substraten dramatisch erhöht.
Kardiomyozyten bilden nach 7 Tagen in Kultur einen einheitlichen, strukturell ausgereiften Monolayer
Kardiomyozyten bilden nach 7 Tagen in Kultur einen einheitlichen, strukturell ausgereiften und hochorganisierten Monolayer. Hier zeigt die Phalloidin-Färbung den hohen Grad der Ausrichtung der zytoskelettalen Komponenten innerhalb der Zellen und innerhalb der Monolayer, im Vergleich zu Kardiomyozyten auf Matrigel. Darüber hinaus exprimieren Kardiomyozyten auf CELLvo™ Matrix Plus im Vergleich zu Matrigel gleichmäßig hohe Troponin I (cTnI)-Spiegel. Dies ist besonders interessant, wenn man bedenkt, dass dieses Gen vorgeburtlich nicht exprimiert wird.
Testen Sie CELLvo™ Matrix Plus noch heute:
StemBioSys beschichtet Ihre Zellkulturplatten und -flaschen individuell mit CELLvo™ Matrix Plus. Bitte kontaktieren Sie bei Interesse info@biozol.de.
Aufgereinigtes Quallenkollagen von Jellagen
![]()
JellaGel™ ist ein Quallen-Kollagen-Hydrogel der nächsten Generation für die In vitro 3D-Zellkultur und das Tissue-Engineering und bietet Kunden eine natürliche, nicht-säugetierische Alternative zu den derzeit auf dem Markt befindlichen Hydrogelen aus Säugetieren und synthetischen Materialien.
Hydrogele sind ein wichtiges Werkzeug für Forscher, die Zellen erfolgreich züchten und erhalten wollen. Zweidimensionale Zellkulturen werden schon seit einiger Zeit verwendet, aber das Wachsen von Zellen in flachen Schichten auf Kunststoffoberflächen bildet den Zustand in vivo nicht genau ab. In Hydrogelen können Zellen wachsen und dank der 3D-Umgebung mit ihrer gesamten Umgebung interagieren. Zellen, die in 3D-Modellen gezüchtet werden, haben sich als physiologisch relevanter erwiesen, mit verbesserter Zelllebensfähigkeit, Morphologie, Proliferation und Differenzierung.
JellaGel bietet Kunden ein biochemisch einfaches, konsistentes und leicht zu verwendendes Hydrogel, das ihre Forschung verändern kann. Eine der großartigsten Eigenschaften von JellaGel ist, dass es bei Raumtemperatur verwendet werden kann, was bedeutet, dass keine Notwendigkeit für Eis oder Kühlräume besteht, im Gegensatz zu einigen Hydrogelen, die derzeit auf dem Markt sind. JellaGel wird aus Quallenkollagen hergestellt, das aufgrund seiner Homogenität zu den Säugetiertypen I, II, III, V und IX als "Kollagen Typ 0" definiert werden kann.
17.05.2021
ChIP-Exo-Seq
Validierte Antikörper von Atlas Antibodies
Analytica 2026
Seien Sie unser Gast!
Gezieltes RNA-Editin...
ADAR-Produkte von SignalChem
Metabolismus-Assays
Oxidativer Stress, Glykolyse und Fettstoffwechsel
Neues Jahr, neue Lab...
Bis zu 80 % Rabatt auf Laborware



